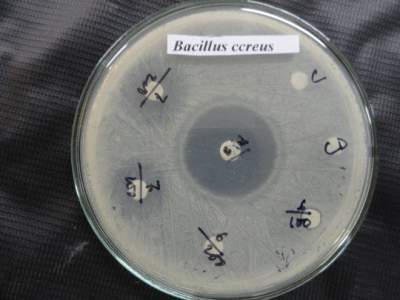
Bacillus ccreus

Volume 1, Issue 2
The Influence of a New-Synthesized Complex Compounds of Co(II), Zn(II) and Cd(II) Containing a Ligand having Tetraoxotetrahydrazin Moiety on some Pathogenic Bacteria
Author(s): M.R. Ullah, Tania Nazneen, A. Hossain*
Department of Chemistry, BUET, Dhaka
Abstract: Some macrocyclic complex compounds of Co(II), Zn(II) and Cd(II) containing a ligand having tetraoxotetrahydrazin moiety are synthesized by template condensation of malonodihydrazide (C3H8N4O2) with different to metal ions through the nitrogen atoms from the tetraoxotetrahydrazin moiety. Antibacterial activity of the derived complex compounds, as well as already used standard compound kanamycin, was tested on five pathogenic bacteria. Given results were then compared to the efficacy of the Antibacterial activity of standard compound kanamycin used for control of these pathogenic bacteria.
Related Graphics:
Fig 1: Photographic representation of zone of inhabitation of the complex 7(3) and the standard compound kanamycin against Bacillus ccreus.

Download Full Article : Click Here
